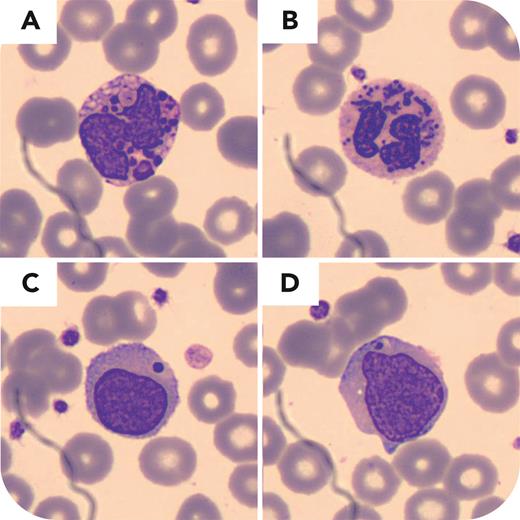
graphic

A 43-month-old boy with a history of prematurity, several episodes of bacterial septicemia, strabismus, and benign Rolandic seizures, without magnetic resonance imaging alterations, was referred to our center. His Moroccan parents were consanguineous cousins. Physical examination revealed skin albinism, light blue eyes, silver hair, and right eye nystagmus. Complete blood count showed hemoglobin 11.7 g/dL, white blood cells 10.4 × 109/L, absolute neutrophil count 0.6 × 109/L, and platelets 398 × 109/L; no biochemistry or coagulation defects were found. A peripheral blood smear stained with May-Grünwald-Giemsa stain was analyzed by digital microscopy (CellaVision) (panels A-D; magnification ×1000). Neutrophils showed multiple abnormally large intracytoplasmic blue-gray granules (panels A-B), and lymphocytes (panels C-D) showed a single, extremely large, round, purple intracytoplasmic granule. The platelets and erythrocytes were normal. Next-generation sequencing of the LYST, HPS1, MLPH, MYO5A, and RAB27A genes revealed a homozygous pathogenic missense mutation (NM_000081.3:c.11173G>A;NP_000072.2:p.G3725R) in the LYST gene, which usually encodes a protein that regulates lysosomal fission and trafficking, confirming the Chédiak-Higashi syndrome diagnosis. Disrupted lysosomal fission results in abnormally large granules.
Although clinical findings could suggest the diagnosis, in complex cases involving cytopenias, the standard workup with a blood smear analysis can help narrow down the differential diagnosis and can even be rapidly diagnostic as illustrated in this case.
For additional images, visit the ASH Image Bank, a reference and teaching tool that is continually updated with new atlas and case study images. For more information, visit https://imagebank.hematology.org.